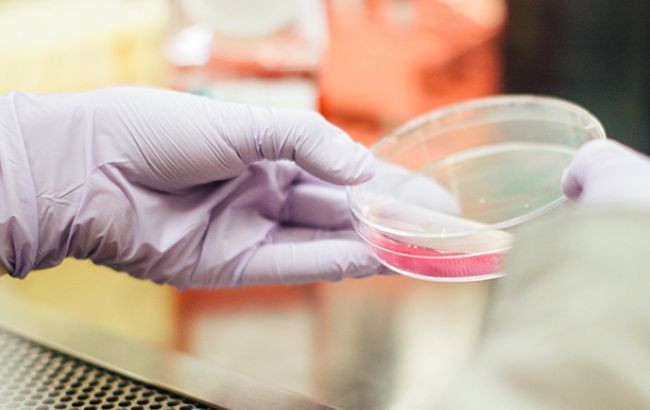
В Киеве уровень заболеваемости гриппом среди школьников вырос на 25%

В Киеве уровень заболеваемости гриппом среди школьников вырос на 25%
Фото: больница (unsplash.com/drew-hays)
Фото: больница (unsplash.com/drew-hays)
В Киеве уровень заболеваемости гриппом и острой респираторной вирусной инфекцией (ОРВИ) среди школьников вырос на 25%. Об этом сообщил первый заместитель председателя Киевской городской государственной администрации Николай Поворозник, передает пресс-служба КГГА.
"Сейчас в городе заболеваемость гриппом и ОРВИ находится на уровне, характерном для данного периода года. Однако по четвертую неделю 2018 года зарегистрирован рост заболеваемости на 11,4%, если сравнивать с предыдущей неделей. Рост произошел за счет детей, и хотя пока преимущественно болеют дошкольники, среди школьников уровень заболеваемости вырос на 25%", - сказал он.
Поворозник сообщил, что в одной из школ приостановят занятия, так как уровень заболеваемости там превысил 20%, отметив, что еще в 14 школах произошло частичное покласове закрытие.
Указано, что наибольшее количество отсутствующих школьников наблюдается в Дарницком, Оболонском, Святошинском и Соломенском районах.
Напомним, Поворозник также сообщил, что школы совместно с районными управлениями образования будут сами принимать решение о приостановке учебного процесса, если болеет более 20% учеников.

